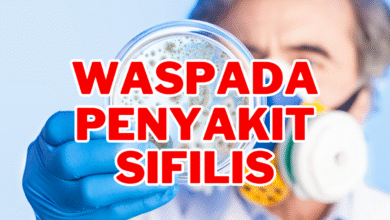

Sifilis
- Agu- 2023 -12 AgustusNews

Pahami Penyakit Sifilis: Penyebab, Penularan, dan Faktor Risiko
Memahami penyakit sifilis atau yang sering disebut sebagai “pemimik hebat” atau “raja singa”. Penyakit ini bisa menular dari individu yang terinfeksi kepada orang lain melalui kontak seksual. Sayangnya, beberapa individu yang terinfeksi mungkin tidak menyadari status sifilisnya karena gejalanya ringan atau bahkan tidak ada sama sekali. Namun demikian, jika sifilis tidak diobati, bisa berakibat serius. Jadi, apa yang menyebabkan sifilis…
Read More »